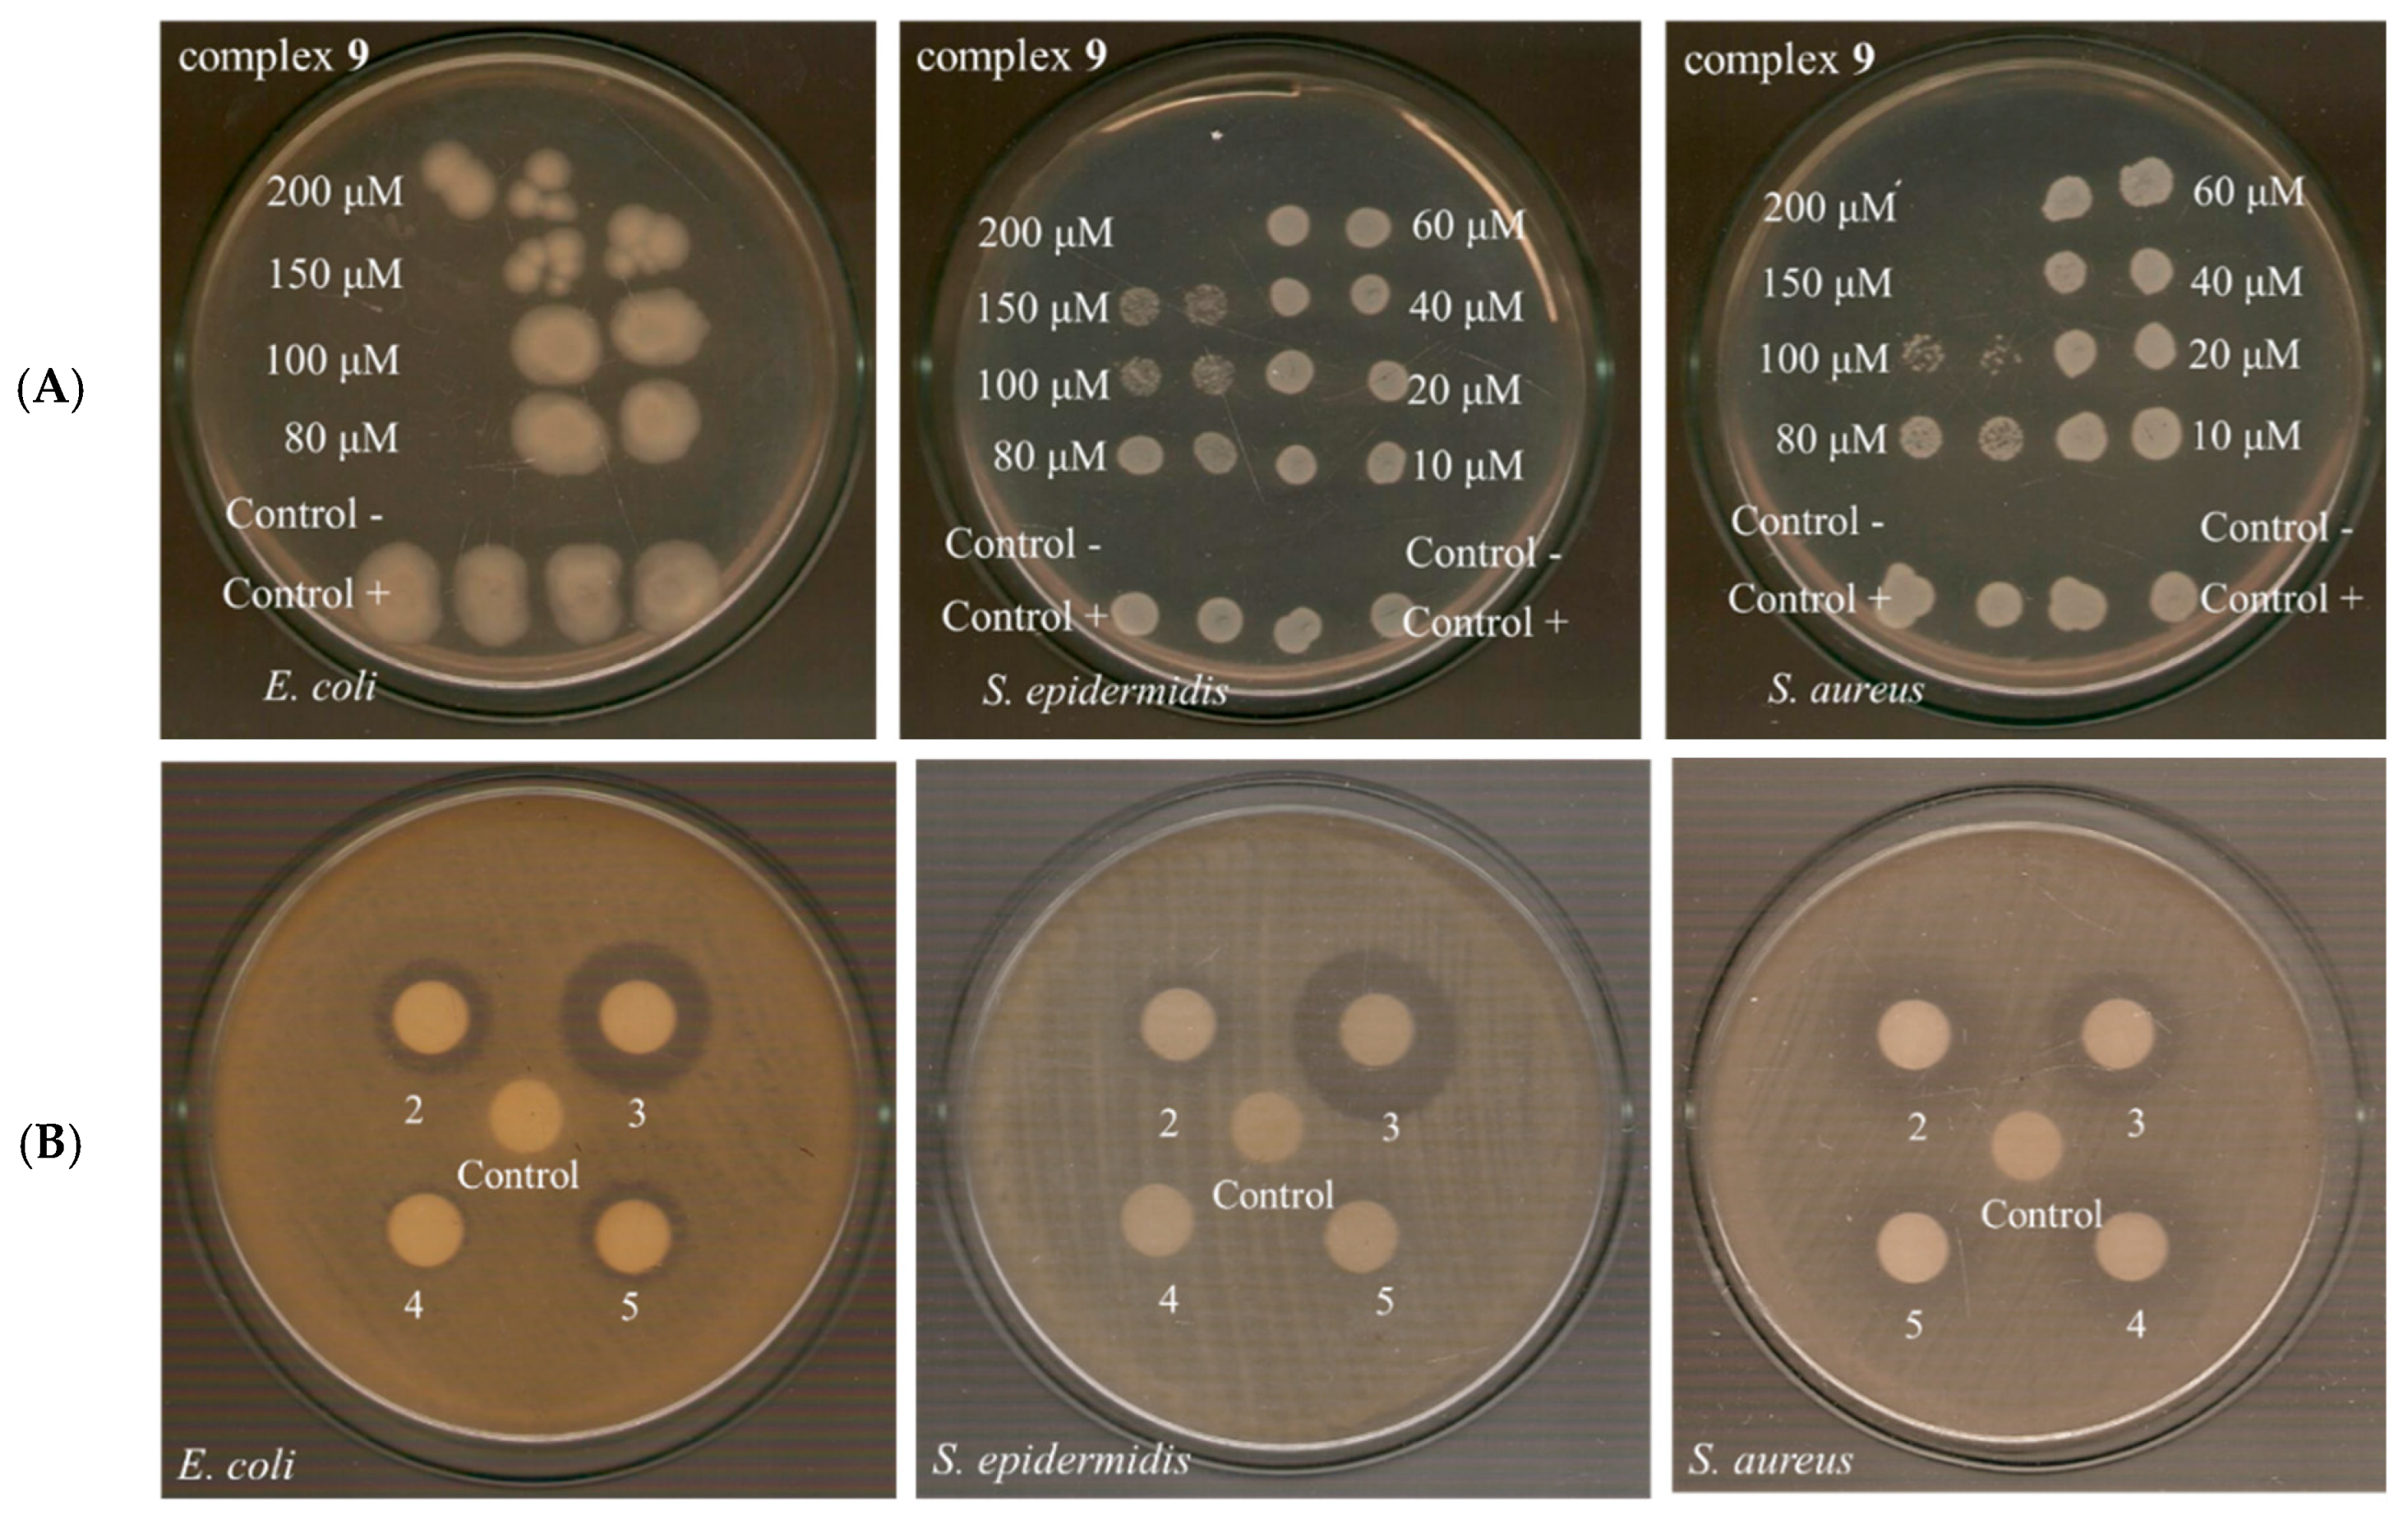
Ijms 26 09787 g004

Cobalt(II) Complexes of 4′-Bromo-Fenamic Acid: Antioxidant Properties, Antibacterial Activity, and Interaction with DNA and Albumins
Abstract
1. Introduction
2. Results and Discussion
2.1. Synthesis and Characterization of the Compounds
2.2. Structure of the Complexes
2.2.1. Crystal Structure of [Co(4′-Br-fen)2(MeOH)4]·2MeOH (Complex 1)
2.2.2. Proposed Structures for Complexes 2–9
2.3. Antioxidant Activity of the Compounds
2.4. Antibacterial Activity
2.4.1. Antibacterial Effect of Compounds on the Growth of Microbial Strains
2.4.2. Minimum Bactericidal Concentration Testing
2.4.3. Determination of the IZ Through Agar Disc-Diffusion Method
2.5. Interaction of the Complexes with CT DNA
2.5.1. Interaction of the Complexes with CT DNA Studied with UV-Vis Spectroscopy
2.5.2. CT DNA Viscosity Measurements
2.5.3. Competitive Studies with EB
2.5.4. Effect of Temperature on the Interaction of the Complexes with CT DNA
2.5.5. Thermodynamic Parameters of the Interaction of the Complexes with CT DNA
2.6. (Photo)Cleavage of pBR322 Plasmid DNA
2.7. Interaction of the Compounds with Serum Albumins
2.7.1. Affinity of the Compounds for Serum Albumins
2.7.2. Determination of the Albumin-Binding Site
3. Materials and Methods
3.1. Materials—Instrumentation- Physical Measurements
3.2. Synthesis and Experimental Data of the Compounds
3.3. X-Ray Crystal Structure Determination
3.4. Study of the Biological Profile of the Compounds
4. Conclusions
Supplementary Materials
Author Contributions
Funding
Institutional Review Board Statement
Informed Consent Statement
Data Availability Statement
Acknowledgments
Conflicts of Interest
Abbreviations
| 4′-Br-fen−1 | 4′-bromofenamato anion |
| 4′-Br-fenH | 4′-bromofenamic acid |
| ABTS | 2,2′-azinobis-(3-ethylbenzothiazoline-6-sulfonic acid) |
| BHT | butylated hydroxytoluene |
| bipyam | 2,2′-bipyridylamine |
| BSA | bovine serum albumin |
| COX | cyclooxygenase |
| CT | calf-thymus |
| dicl−1 | anion of diclofenac |
| DPPH | 1,1-diphenyl-picrylhydrazyl |
| E. coli | Escherichia coli |
| EB | ethidium bromide |
| fen−1 | fenamato anion |
| fluf−1 | flufenamato anion |
| Hdicl | diclofenac |
| Hfen | fenamic acid |
| Hfluf | flufenamic acid |
| Himi | 1H-imidazole |
| Hmeclf | meclofenamic acid |
| Hmef | mefenamic acid |
| Hnap | naproxen |
| Hnif | niflumic acid |
| HSA | human serum albumin |
| Htolf | tolfenamic acid |
| IZ | inhibition zone |
| K | SA-binding constant |
| Kb | DNA-binding constant |
| Kq | quenching constant |
| KSV | Stern-Volmer constant |
| MBC | minimum bactericidal concentration |
| meclf−1 | meclofenamato anion |
| mef−1 | mefenamato anion |
| MIC | minimum inhibitory concentration |
| nap−1 | anion of naproxen |
| NDGA | nordihydroguaiaretic acid |
| neoc | neocuproine (2,9-dimethyl-1,10-phenanthroline) |
| nif−1 | niflumato anion |
| NSAID | non-steroidal anti-inflammatory drug |
| P. aeruginosa | Pseudomonas aeruginosa |
| pDNA | pBR322 plasmid DNA |
| phen | 1,10-phenanthroline |
| py | pyridine |
| ROS | reactive oxygen species |
| RT | room temperature |
| S. aureus | Staphylococcus aureus |
| S. epidermidis | Staphylococcus epidermidis |
| SA | serum albumin |
| Tm | DNA-melting temperature |
| tolf−1 | tolfenamato anion |
| trolox | 6-hydroxy-2,5,7,8-tetramethylchroman-2-carboxylic acid |
| αpic | α-picoline (2-methylpyridine) |
| βpic | β-picoline (3-methylpyridine) |
| γpic | γ-picoline (4-methylpyridine) |
References
- Wongrakpanich, S.; Wongrakpanich, A.; Melhado, K.; Rangaswami, J. A Comprehensive Review of Non-Steroidal Anti-Inflammatory Drug Use in The Elderly. Aging Dis. 2018, 9, 143–150. [Google Scholar] [CrossRef]
- Santos, A.C.F.; Monteiro, L.P.G.; Gomes, A.C.C.; Martel, F.; Santos, T.M.; Ferreira, B.J.M.L. NSAID-Based Coordination Compounds for Biomedical Applications: Recent Advances and Developments. Int. J. Mol. Sci. 2022, 23, 2855. [Google Scholar] [CrossRef] [PubMed]
- Fang, J.; Orobator, O.N.; Olelewe, C.; Passeri, G.; Singh, K.; Awuah, S.G.; Suntharalingam, K. A Breast Cancer Stem Active Cobalt(III)-Cyclam Complex Containing Flufenamic Acid with Immunogenic Potential. Angew. Chem. 2024, 136, e202317940. [Google Scholar] [CrossRef]
- Prasher, P.; Sharma, M. Medicinal Chemistry of Anthranilic Acid Derivatives: A Mini Review. Drug Dev. Res. 2021, 82, 945–958. [Google Scholar] [CrossRef]
- Cain, B.F.; Atwell, G.J. Potential Antitumor Agents. 19. Multiply Substituted 4′-(9-Acridinylamino)Methanesulfonanilides. J. Med. Chem. 1976, 19, 1124–1129. [Google Scholar] [CrossRef] [PubMed]
- Nawaz, H.; Ali, A.; Rehman, T.; Aslam, A. Chronological Effects of Non-Steroidal Anti-Inflammatory Drug Therapy on Oxidative Stress and Antioxidant Status in Patients with Rheumatoid Arthritis. Clin. Rheumatol. 2021, 40, 1767–1778. [Google Scholar] [CrossRef]
- Fu, Z.; Wiriyarattanakul, A.; Xie, W.; Jantorn, P.; Toopradab, B.; Shi, L.; Rungrotmongkol, T.; Maitarad, P. Antioxidant Activity of NSAIDs-Se Derivatives: Predictive QSAR-Machine Learning Models. New J. Chem. 2024, 48, 16359–16368. [Google Scholar] [CrossRef]
- Sharma, U.; Sahu, A.; Shekhar, H.; Sharma, B.; Haque, S.; Kaur, D.; Tuli, H.S.; Mishra, A.; Ahmad, F. The Heat of the Battle: Inflammation’s Role in Prostate Cancer Development and Inflammation-Targeted Therapies. Discov. Oncol. 2025, 16, 108. [Google Scholar] [CrossRef]
- Dewangan, R.; Agrawal, N.; Lanjhiyana, S.K.; Jaiswal, M. Exploring the Antineoplastic Potential of Novel NSAID Derivatives in Combatting Mammary Tumorigenesis: A Comprehensive Review. Med. Chem. Res. 2025, 34, 764–790. [Google Scholar] [CrossRef]
- Kolawole, O.R.; Kashfi, K. NSAIDs and Cancer Resolution: New Paradigms beyond Cyclooxygenase. Int. J. Mol. Sci. 2022, 23, 1432. [Google Scholar] [CrossRef]
- Khan, H.Y.; Parveen, S.; Yousuf, I.; Tabassum, S.; Arjmand, F. Metal Complexes of NSAIDs as Potent Anti-Tumor Chemotherapeutics: Mechanistic Insights into Cytotoxic Activity via Multiple Pathways Primarily by Inhibition of COX-1 and COX-2 Enzymes. Coord. Chem. Rev. 2022, 453, 214316. [Google Scholar] [CrossRef]
- Iftode, C.; Olaru, I.; Chioran, D.; Coricovac, D.; Geamantan, A.; Borza, C.; Ursoniu, S.; Ardelean, S. Non-Steroidal Anti-Inflammatory Drugs (NSAIDs) as Repurposed Anticancer Drugs in Skin Cancer. Farmacia 2024, 72, 28–43. [Google Scholar] [CrossRef]
- Chen, Y.; Zhang, Y.; Chen, S.; Liu, W.; Lin, Y.; Zhang, H.; Yu, F. Non-Steroidal Anti-Inflammatory Drugs (NSAIDs) Sensitize Melanoma Cells to MEK Inhibition and Inhibit Metastasis and Relapse by Inducing Degradation of AXL. Pigment Cell Melanoma Res. 2022, 35, 238–251. [Google Scholar] [CrossRef]
- Moura, N.M.M.; Castro, K.A.D.F.; Biazzotto, J.C.; Prandini, J.A.; Lodeiro, C.; Faustino, M.A.F.; Simões, M.M.Q.; da Silva, R.S.; Neves, M.G.P.M.S. Ruthenium and Iridium Complexes Bearing Porphyrin Moieties: PDT Efficacy against Resistant Melanoma Cells. Dyes Pigments 2022, 205, 110501. [Google Scholar] [CrossRef]
- Muskovic, M.; Loncaric, M.; Ratkaj, I.; Malatesti, N. Impact of the Hydrophilic-Lipophilic Balance of Free-Base and Zn(II) Tricationic Pyridiniumporphyrins and Irradiation Wavelength in PDT against the Melanoma Cell Lines. Eur. J. Med. Chem. 2025, 282, 117063. [Google Scholar] [CrossRef]
- Mikra, C.; Mitrakas, A.; Ghizzani, V.; Katsani, K.R.; Koffa, M.; Koukourakis, M.; Psomas, G.; Protti, S.; Fagnoni, M.; Fylaktakidou, K.C. Effect of Arylazo Sulfones on DNA: Binding, Cleavage, Photocleavage, Molecular Docking Studies and Interaction with A375 Melanoma and Non-Cancer Cells. Int. J. Mol. Sci. 2023, 24, 1834. [Google Scholar] [CrossRef]
- Mitrakas, A.; Stathopoulou, M.E.K.; Mikra, C.; Konstantinou, C.; Rizos, S.; Malichetoudi, S.; Koumbis, A.E.; Koffa, M.; Fylaktakidou, K.C. Synthesis of 2-Amino-N′-Aroyl(Het)Arylhydrazides, DNA Photocleavage, Molecular Docking and Cytotoxicity Studies against Melanoma CarB Cell Lines. Molecules 2024, 29, 647. [Google Scholar] [CrossRef] [PubMed]
- Kakoulidou, C.; Gritzapis, P.S.; Hatzidimitriou, A.G.; Fylaktakidou, K.C.; Psomas, G. Zn(II) Complexes of (E)-4-(2-(Pyridin-2-Ylmethylene)Hydrazinyl)Quinazoline in Combination with Non-Steroidal Anti-Inflammatory Drug Sodium Diclofenac: Structure, DNA Binding and Photo-Cleavage Studies, Antioxidant Activity and Interaction with Albumin. J. Inorg. Biochem. 2020, 211, 111194. [Google Scholar] [CrossRef] [PubMed]
- Kakoulidou, C.; Chasapis, C.T.; Hatzidimitriou, A.G.; Fylaktakidou, K.C.; Psomas, G. Transition Metal(II) Complexes of Halogenated Derivatives of (E)-4-(2-(Pyridin-2-Ylmethylene)Hydrazinyl)Quinazoline: Structure, Antioxidant Activity, DNA-Binding DNA Photocleavage, Interaction with Albumin and in Silico Studies. Dalton Trans. 2022, 51, 16688–16705. [Google Scholar] [CrossRef] [PubMed]
- Krishnendu, P.R.; Arjun, B.; Vibina, K.; Cleo, T.S.N.; Drisya, N.K.; Mohandas, R.; Zachariah, S.M. Review on Evaluating the Role of NSAIDs for the Treatment of Alzheimer’s Disease. Int. J. Appl. Pharm. 2021, 13, 91–94. [Google Scholar] [CrossRef]
- Leao, C.; Borges, A.; Simoes, M. NSAIDs as a Drug Repurposing Strategy for Biofilm Control. Antibiotics 2020, 9, 591. [Google Scholar] [CrossRef]
- Desai, A.; Desai, A.; Chougule, N. Understanding Dysmenorrhea: A Comprehensive Overview. J. Med. Plants Stud. 2024, 12, 70–75. [Google Scholar]
- Elgohary, M.K.; Elkotamy, M.S.; Abdelrahman Alkabbani, M.; Abdel-Aziz, H.A. Fenamates and Ibuprofen as Foundational Components in the Synthesis of Innovative, Targeted COX-2 Anti-Inflammatory Drugs, Undergoing Thorough Biopharmacological Assessments and in-Silico Computational Studies. Bioorg. Chem. 2024, 147, 107393. [Google Scholar] [CrossRef]
- Li, J.; Wang, X.; Zhang, H.; Hu, X.; Peng, X.; Jiang, W.; Zhuo, L.; Peng, Y.; Zeng, G.; Wang, Z. Fenamates: Forgotten Treasure for Cancer Treatment and Prevention: Mechanisms of Action, Structural Modification, and Bright Future. Med. Res. Rev. 2025, 45, 164–213. [Google Scholar] [CrossRef]
- Hill, J.; Zawia, N.H. Fenamates as Potential Therapeutics for Neurodegenerative Disorders. Cells 2021, 10, 702. [Google Scholar] [CrossRef]
- Alrouji, M.; Al-Kuraishy, H.M.; Al-Gareeb, A.I.; Saad, H.M.; Batiha, G.E.-S. A Story of the Potential Effect of Non-Steroidal Anti-Inflammatory Drugs (NSAIDs) in Parkinson’s Disease: Beneficial or Detrimental Effects. Inflammopharmacology 2023, 31, 673–688. [Google Scholar] [CrossRef]
- Kalembkiewicz, J.; Kosinska, M.; Zapala, L. Complexes of Aminobenzoic Acids: A Comprehensive Review Concerning Synthesis, Physical Chemistry, Structure and Application. Coord. Chem. Rev. 2017, 348, 25–53. [Google Scholar] [CrossRef]
- Tseng, H.J.; Lin, M.H.; Shiao, Y.J.; Yang, Y.C.; Chu, J.C.; Chen, C.Y.; Chen, Y.Y.; Lin, T.E.; Su, C.J.; Pan, S.L.; et al. Synthesis and Biological Evaluation of Acridine-Based Histone Deacetylase Inhibitors as Multitarget Agents against Alzheimer’s Disease. Eur. J. Med. Chem. 2020, 192, 112193. [Google Scholar] [CrossRef] [PubMed]
- Manzoor, M.; Solangi, M.; Perveen, S.; Salar, U.; Naz, F.; Iqbal, J.; Hussain, Z.; Imran, A.; Taha, M.; Khan, K.M. Exploring Tricycle Acridines as Prospective Urease Inhibitors: Synthesis via Microwave Assistance, in Vitro Evaluation, Kinetic Profiling, and Molecular Docking Investigations. J. Iran. Chem. Soc. 2024, 21, 1163–1183. [Google Scholar] [CrossRef]
- Sharma, S.K.; Fraser, W. Selectivity of a Bromoacridine-Containing Fluorophore for Triplex DNA. Monatsh. Chem. 2021, 152, 1013–1016. [Google Scholar] [CrossRef]
- Askarzadeh, M.; Moazzam, A.; Sayahi, M.H.; Fouladvand, A.; Adib, M.; Mahdavi, M. Eco-Friendly, Green and New Metal-Free Intramolecular Friedel-Crafts Reaction to Synthesis of Acridones Derivatives Using Phenylboronic Acid Derivatives. Tetrahedron Lett. 2023, 123, 154532. [Google Scholar] [CrossRef]
- Jing, D.; Lu, C.; Chen, Z.; Jin, S.; Xie, L.; Meng, Z.; Su, Z.; Zheng, K. Light-Driven Intramolecular C-N Cross-Coupling via a Long-Lived Photoactive Photoisomer Complex. Angew. Chem. 2019, 131, 14808–14814. [Google Scholar] [CrossRef]
- Hao, X.; Deng, J.; Zhang, H.; Liang, Z.; Lei, F.; Wang, Y.; Yang, X.; Wang, Z. Design, Synthesis and Bioactivity Evaluation of Novel N-Phenyl-Substituted Evodiamine Derivatives as Potent Anti-Tumor Agents. Bioorg. Med. Chem. 2022, 55, 116595. [Google Scholar] [CrossRef]
- Liang, Y.; Zhang, H.; Zhang, X.; Peng, Y.; Deng, J.; Wang, Y.; Li, R.; Liu, L.; Wang, Z. Discovery of Evodiamine Derivatives as Potential Lead Antifungal Agents for the Treatment of Superficial Fungal Infections. Bioorg. Chem. 2022, 127, 105981. [Google Scholar] [CrossRef]
- Liu, Z.; Duan, Z.; Zhang, D.; Xiao, P.; Zhang, T.; Xu, H.; Wang, C.H.; Rao, G.W.; Gan, J.; Huang, Y.; et al. Structure-Activity Relationships and Antileukemia Effects of the Tricyclic Benzoic Acid FTO Inhibitors. J. Med. Chem. 2022, 65, 10638–10654. [Google Scholar] [CrossRef]
- Fan, X.; Li, J.; Long, L.; Shi, T.; Liu, D.; Tan, W.; Zhang, H.; Wu, X.; Lei, X.; Wang, Z. Design, Synthesis and Biological Evaluation of N-Anthraniloyl Tryptamine Derivatives as Pleiotropic Molecules for the Therapy of Malignant Glioma. Eur. J. Med. Chem. 2021, 222, 113564. [Google Scholar] [CrossRef]
- Ramanujam, P.; Asthana, J.G. Antifungal Activity of Some N Substituted Anthranilic Acid Derivatives. Planta Med. 1974, 25, 43–46. [Google Scholar] [CrossRef]
- Englert, H.C.; Hropot, M.; Lang, H.; Greger, R. Use of Amino-Substituted Benzoic Acids as Remedies for Diarrhea, and Medicaments Based on These Compounds. U.S. Patent No. 4921875, 1 May 1990. [Google Scholar]
- Banti, C.N.; Hadjikakou, S.K. Non-Steroidal Anti-Inflammatory Drugs (NSAIDs) in Metal Complexes and Their Effect at the Cellular Level. Eur. J. Inorg. Chem. 2016, 2016, 3048–3071. [Google Scholar] [CrossRef]
- Psomas, G. Copper(II) and Zinc(II) Coordination Compounds of Non-Steroidal Anti-Inflammatory Drugs: Structural Features and Antioxidant Activity. Coord. Chem. Rev. 2020, 412, 213259. [Google Scholar] [CrossRef]
- Petronijevic, J.; Joksimovic, N.; Milovic, E.; Crnogorac, M.D.; Petrovic, N.; Stanojkovic, T.; Milivojevic, D.; Jankovic, N. Antitumor Activity, DNA and BSA Interactions of Novel Copper(II) Complexes with 3,4-Dihydro-2(1H)-Quinoxalinones. Chem. Biol. Interact. 2021, 348, 109647. [Google Scholar] [CrossRef] [PubMed]
- Joksimovic, N.; Petronijevic, J.; Cocic, D.; Ristic, M.; Mihajlovic, K.; Jankovic, N.; Milovic, E.; Klisuric, O.; Petrovic, N.; Kosanic, M. Synthesis, Characterization, and Biological Evaluation of Novel Cobalt(II) Complexes with β-Diketonates: Crystal Structure Determination, BSA Binding Properties and Molecular Docking Study. JBIC J. Biol. Inorg. Chem. 2024, 29, 541–553. [Google Scholar] [CrossRef]
- Zoroddu, M.A.; Aaseth, J.; Crisponi, G.; Medici, S.; Peana, M.; Nurchi, V.M. The Essential Metals for Humans: A Brief Overview. J. Inorg. Biochem. 2019, 195, 120–129. [Google Scholar] [CrossRef]
- Genchi, G.; Lauria, G.; Catalano, A.; Carocci, A.; Sinicropi, M.S. Prevalence of Cobalt in the Environment and Its Role in Biological Processes. Biology 2023, 12, 1335. [Google Scholar] [CrossRef]
- Islam, M.d.R.; Akash, S.; Jony, M.H.; Alam, M.d.N.; Nowrin, F.T.; Rahman, M.d.M.; Rauf, A.; Thiruvengadam, M. Exploring the Potential Function of Trace Elements in Human Health: A Therapeutic Perspective. Mol. Cell. Biochem. 2023, 478, 2141–2171. [Google Scholar] [CrossRef]
- Heffern, M.C.; Yamamoto, N.; Holbrook, R.J.; Eckermann, A.L.; Meade, T.J. Cobalt Derivatives as Promising Therapeutic Agents. Curr. Opin. Chem. Biol. 2013, 17, 189–196. [Google Scholar] [CrossRef]
- Dimiza, F.; Papadopoulos, A.N.; Tangoulis, V.; Psycharis, V.; Raptopoulou, C.P.; Kessissoglou, D.P.; Psomas, G. Biological Evaluation of Cobalt(II) Complexes with Non-Steroidal Anti-Inflammatory Drug Naproxen. J. Inorg. Biochem. 2012, 107, 54–64. [Google Scholar] [CrossRef]
- Dimiza, F.; Papadopoulos, A.N.; Tangoulis, V.; Psycharis, V.; Raptopoulou, C.P.; Kessissoglou, D.P.; Psomas, G. Biological Evaluation of Non-Steroidal Anti-Inflammatory Drugs-Cobalt(II) Complexes. Dalton Trans. 2010, 39, 4517–4528. [Google Scholar] [CrossRef] [PubMed]
- Perontsis, S.; Hatzidimitriou, A.G.; Psomas, G. Coordination Compounds of Cobalt(II) with Carboxylate Non-Steroidal Anti-Inflammatory Drugs: Structure and Biological Profile. Dalton Trans. 2024, 53, 15215–15235. [Google Scholar] [CrossRef] [PubMed]
- Perontsis, S.; Dimitriou, A.; Fotiadou, P.; Hatzidimitriou, A.G.; Papadopoulos, A.N.; Psomas, G. Cobalt(II) Complexes with the Non-Steroidal Anti-Inflammatory Drug Diclofenac and Nitrogen-Donor Ligands. J. Inorg. Biochem. 2019, 196, 110688. [Google Scholar] [CrossRef]
- Perontsis, S.; Geromichalou, E.; Perdih, F.; Hatzidimitriou, A.G.; Geromichalos, G.D.; Turel, I.; Psomas, G. Synthesis, Structural Determination, in Vitro and in Silico Biological Evaluation of Divalent or Trivalent Cobalt Complexes with Indomethacin. J. Inorg. Biochem. 2020, 212, 111213. [Google Scholar] [CrossRef] [PubMed]
- Tsiliou, S.; Kefala, L.A.; Perdih, F.; Turel, I.; Kessissoglou, D.P.; Psomas, G. Cobalt(II) Complexes with Non-Steroidal Anti-Inflammatory Drug Tolfenamic Acid: Structure and Biological Evaluation. Eur. J. Med. Chem. 2012, 48, 132–142. [Google Scholar] [CrossRef] [PubMed]
- Tsiliou, S.; Kefala, L.A.; Hatzidimitriou, A.G.; Kessissoglou, D.P.; Perdih, F.; Papadopoulos, A.N.; Turel, I.; Psomas, G. Cobalt(II) Complexes with Non-Steroidal Anti-Inflammatory Drugs and α-Diimines. J. Inorg. Biochem. 2016, 160, 125–139. [Google Scholar] [CrossRef]
- Malis, G.; Roussa, A.; Papantopoulou, E.A.; Kalogiannis, S.; Hatzidimitriou, A.G.; Fylaktakidou, K.C.; Psomas, G. Cobalt(II) Complexes of 4′-Nitro-Fenamic Acid: Characterization and Biological Evaluation. Molecules 2025, 30, 2621. [Google Scholar] [CrossRef]
- Kakoulidou, C.; Kosmas, V.R.; Hatzidimitriou, A.G.; Fylaktakidou, K.C.; Psomas, G. Structure and Biological Profile of Transition Metal Complexes with (E)-4-(2-(Pyridin-2-Ylmethylene)Hydrazinyl)Quinazoline. J. Inorg. Biochem. 2021, 219, 111448. [Google Scholar] [CrossRef]
- Monka, M.; Gogoc, S.; Kozakiewicz, K.; Ievtukhov, V.; Grzywacz, D.; Ciupak, O.; Kubicki, A.; Bojarski, P.; Data, P.; Serdiuk, I.E. Application of the Heavy-Atom Effect for (Sub)Microsecond Thermally Activated Delayed Fluorescence and an All-Organic Light-Emitting Device with Low-Efficiency Roll-Off. ACS Appl. Mater. Interfaces 2024, 16, 15107–15120. [Google Scholar] [CrossRef]
- Haider, M.R.; Ahmad, K.; Siddiqui, N.; Ali, Z.; Akhtar, M.J.; Fuloria, N.; Fuloria, S.; Ravichandran, M.; Yar, M.S. Novel 9-(2-(1-Arylethylidene)Hydrazinyl)Acridine Derivatives: Target Topoisomerase 1 and Growth Inhibition of HeLa Cancer Cells. Bioorg. Chem. 2019, 88, 102962. [Google Scholar] [CrossRef] [PubMed]
- Martin, A.; Pellon, R.F.; Mesa, M.; Docampo, M.L.; Gomez, V. Microwave-Assisted Synthesis of N-Phenylanthranilic Acids in Water. J. Chem. Res. 2005, 2005, 561–563. [Google Scholar] [CrossRef]
- Geary, W.J. The Use of Conductivity Measurements in Organic Solvents for the Characterisation of Coordination Compounds. Coord. Chem. Rev. 1971, 7, 81–122. [Google Scholar] [CrossRef]
- Nakamoto, K. Infrared and Raman Spectra of Inorganic and Coordination Compounds, Part B: Applications in Coordination, Organometallic, and Bioinorganic Chemistry; John Wiley & Sons: Hoboken, NJ, USA, 2008; pp. 1–408. [Google Scholar] [CrossRef]
- Szorcsik, A.; Nagy, L.; Sletten, J.; Szalontai, G.; Kamu, E.; Fiore, T.; Pellerito, L.; Kálmán, E. Preparation and Structural Studies on Dibutyltin(IV) Complexes with Pyridine Mono- and Dicarboxylic Acids. J. Organomet. Chem. 2004, 689, 1145–1154. [Google Scholar] [CrossRef]
- Bernhardt, P.V.; Lawrance, G.A. Cobalt. In Comprehensive Coordination Chemistry II; Elsevier: Oxford, UK, 2003; pp. 1–145. [Google Scholar]
- Tarushi, A.; Raptopoulou, C.P.; Psycharis, V.; Kessissoglou, D.P.; Papadopoulos, A.N.; Psomas, G. Interaction of Zinc(II) with the Non-Steroidal Anti-Inflammatory Drug Niflumic Acid. J. Inorg. Biochem. 2017, 176, 100–112. [Google Scholar] [CrossRef] [PubMed]
- Tsiliki, P.; Perdih, F.; Turel, I.; Psomas, G. Structure, DNA- and Albumin-Binding of the Manganese(II) Complex with the Non-Steroidal Antiinflammatory Drug Niflumic Acid. Polyhedron 2013, 53, 215–222. [Google Scholar] [CrossRef]
- Kontogiorgis, C.; Ntella, M.; Mpompou, L.; Karallaki, F.; Athanasios, P.; Hadjipavlou-Litina, D.; Lazari, D. Study of the Antioxidant Activity of Thymus sibthorpii Bentham (Lamiaceae). J. Enzyme Inhib. Med. Chem. 2016, 31, 154–159. [Google Scholar] [CrossRef] [PubMed]
- Ali, B.M.; Boothapandi, M.; Sultan Nasar, A.S. Nitric Oxide, DPPH and Hydrogen Peroxide Radical Scavenging Activity of TEMPO Terminated Polyurethane Dendrimers: Data Supporting Antioxidant Activity of Radical Dendrimers. Data Brief 2020, 28, 104972. [Google Scholar] [CrossRef] [PubMed]
- Dairi, S.; Carbonneau, M.A.; Galeano-Diaz, T.; Remini, H.; Dahmoune, F.; Aoun, O.; Belbahi, A.; Lauret, C.; Cristol, J.P.; Madani, K. Antioxidant Effects of Extra Virgin Olive Oil Enriched by Myrtle Phenolic Extracts on Iron-Mediated Lipid Peroxidation under Intestinal Conditions Model. Food Chem. 2017, 237, 297–304. [Google Scholar] [CrossRef]
- Kontogiorgis, C.; Hadjipavlou-Litina, D. Biological Evaluation of Several Coumarin Derivatives Designed as Possible Anti-Inflammatory/Antioxidant Agents. J. Enzyme Inhib. Med. Chem. 2003, 18, 63–69. [Google Scholar] [CrossRef]
- Dimiza, F.; Fountoulaki, S.; Papadopoulos, A.N.; Kontogiorgis, C.A.; Tangoulis, V.; Raptopoulou, C.P.; Psycharis, V.; Terzis, A.; Kessissoglou, D.P.; Psomas, G. Non-Steroidal Antiinflammatory Drug-Copper(II) Complexes: Structure and Biological Perspectives. Dalton Trans. 2011, 40, 8555–8568. [Google Scholar] [CrossRef]
- Re, R.; Pellegrini, N.; Proteggente, A.; Pannala, A.; Yang, M.; Rice-Evans, C. Antioxidant Activity Applying an Improved ABTS Radical Cation Decolorization Assay. Free Radic. Biol. Med. 1999, 26, 1231–1237. [Google Scholar] [CrossRef]
- Ruch, R.J.; Cheng, S.J.; Klaunig, J.E. Prevention of Cytotoxicity and Inhibition of Intercellular Communication by Antioxidant Catechins Isolated from Chinese Green Tea. Carcinogenesis 1989, 10, 1003–1008. [Google Scholar] [CrossRef]
- Wettasinghe, M.; Shahidi, F. Scavenging of Reactive-Oxygen Species and DPPH Free Radicals by Extracts of Borage and Evening Primrose Meals. Food Chem. 2000, 70, 17–26. [Google Scholar] [CrossRef]
- Smolkova, R.; Smolko, L.; Samolova, E.; Dusek, M. Co(II) Fenamato, Tolfenamato and Niflumato Complexes with Neocuproine: Synthesis, Crystal Structure, Spectral Characterization and Biological Activity. J. Mol. Struct. 2023, 1272, 134772. [Google Scholar] [CrossRef]
- Banti, C.N.; Kapetana, M.; Papachristodoulou, C.; Raptopoulou, C.P.; Psycharis, V.; Zoumpoulakis, P.; Mavromoustakos, T.; Hadjikakou, S.K. Hydrogels Containing Water Soluble Conjugates of Silver(I) Ions with Amino Acids, Metabolites or Natural Products for Non Infectious Contact Lenses. Dalton Trans. 2021, 50, 13712–13727. [Google Scholar] [CrossRef]
- Milionis, I.; Banti, C.N.; Sainis, I.; Raptopoulou, C.P.; Psycharis, V.; Kourkoumelis, N.; Hadjikakou, S.K. Silver Ciprofloxacin (CIPAG): A Successful Combination of Chemically Modified Antibiotic in Inorganic-Organic Hybrid. J. Biol. Inorg. Chem. 2018, 23, 705–723. [Google Scholar] [CrossRef] [PubMed]
- Chrysouli, M.P.; Banti, C.N.; Kourkoumelis, N.; Moushi, E.E.; Tasiopoulos, A.J.; Douvalis, A.; Papachristodoulou, C.; Hatzidimitriou, A.G.; Bakas, T.; Hadjikakou, S.K. Ciprofloxacin Conjugated to Diphenyltin(IV): A Novel Formulation with Enhanced Antimicrobial Activity. Dalton Trans. 2020, 49, 11522–11535. [Google Scholar] [CrossRef]
- Rossmoore, H.W. Part III: Sterilants, Disinfectants, and Antiseptics—Nitrogen Compounds. In Disinfection, Sterilization, and Preservation; Block, S.S., Ed.; Lippincott Williams & Wilkins: Philadelphia, PA, USA, 2001; pp. 393–414. [Google Scholar]
- Russell, A.D. Principles of Antimicrobial Activity and Resistance. In Disinfection, Sterilization and Preservation; Block, S.S., Ed.; Lippincott Williams & Wilkins: Philadelphia, PA, USA, 2001; pp. 31–56. [Google Scholar]
- Stathopoulou, M.E.K.; Banti, C.N.; Kourkoumelis, N.; Hatzidimitriou, A.G.; Kalampounias, A.G.; Hadjikakou, S.K. Silver Complex of Salicylic Acid and Its Hydrogel-Cream in Wound Healing Chemotherapy. J. Inorg. Biochem. 2018, 181, 41–55. [Google Scholar] [CrossRef]
- Shungu, D.L.; Weinberg, E.; Gadebusch, H.H. Tentative Interpretive Standards for Disk Diffusion Susceptibility Testing with Norfloxacin (MK-0366, AM-715). Antimicrob. Agents Chemother. 1983, 23, 256–260. [Google Scholar] [CrossRef]
- Zeglis, B.M.; Pierre, V.C.; Barton, J.K.; Pierre, V.C. Metallo-Intercalators and Metallo-Insertors. Chem. Commun. 2007, 44, 4565–4579. [Google Scholar] [CrossRef]
- Pages, B.J.; Ang, D.L.; Wright, E.P.; Aldrich-Wright, J.R. Metal Complex Interactions with DNA. Dalton Trans. 2015, 44, 3505–3526. [Google Scholar] [CrossRef] [PubMed]
- Pyle, A.M.; Rehmann, J.P.; Meshoyrer, R.; Kumar, C.V.; Turro, N.J.; Barton, J.K. Mixed-Ligand Complexes of Ruthenium(II): Factors Governing Binding to DNA. J. Am. Chem. Soc. 2002, 111, 3051–3058. [Google Scholar] [CrossRef]
- Wolfe, A.; Shimer, G.H.; Meehan, T. Polycyclic Aromatic Hydrocarbons Physically Intercalate into Duplex Regions of Denatured DNA. Biochemistry 1987, 26, 6392–6396. [Google Scholar] [CrossRef] [PubMed]
- Dimitrakopoulou, A.; Dendrinou-Samara, C.; Pantazaki, A.A.; Alexiou, M.; Nordlander, E.; Kessissoglou, D.P. Synthesis, Structure and Interactions with DNA of Novel Tetranuclear, [Mn4(II/II/II/IV)] Mixed Valence Complexes. J. Inorg. Biochem. 2008, 102, 618–628. [Google Scholar] [CrossRef]
- Smolko, L.; Smolkova, R.; Samolova, E.; Morgan, I.; Saoud, M.; Kaluderovic, G.N. Two Isostructural Co(II) Flufenamato and Niflumato Complexes with Bathocuproine: Analogues with a Different Cytotoxic Activity. J. Inorg. Biochem. 2020, 210, 111160. [Google Scholar] [CrossRef]
- Smolkova, R.; Zelenak, V.; Smolko, L.; Dusek, M. Three Variants of Novel Co(II) Complex with NSAID Mefenamic Acid and N,N′-Donor Ligand Neocuproine. Z. Kristallogr. Cryst. Mater. 2016, 231, 715–724. [Google Scholar] [CrossRef]
- Dilek, E.; Caglar, S.; Dogancay, N.; Caglar, B.; Sahin, O.; Tabak, A. Synthesis, Crystal Structure, Spectroscopy, Thermal Properties and Carbonic Anhydrase Activities of New Metal(II) Complexes with Mefenamic Acid and Picoline Derivatives. J. Coord. Chem. 2017, 70, 2833–2852. [Google Scholar] [CrossRef]
- Pizarro, A.M.; Sadler, P.J. Unusual DNA Binding Modes for Metal Anticancer Complexes. Biochimie 2009, 91, 1198–1211. [Google Scholar] [CrossRef] [PubMed]
- Lakowicz, J.R. Principles of Fluorescence Spectroscopy; Springer: Boston, MA, USA, 2006; ISBN 0387312781. [Google Scholar]
- Heller, D.P.; Greenstock, C.L. Fluorescence Lifetime Analysis of DNA Intercalated Ethidium Bromide and Quenching by Free Dye. Biophys. Chem. 1994, 50, 305–312. [Google Scholar] [CrossRef]
- Wittwer, C.T.; Hemmert, A.C.; Kent, J.O.; Rejali, N.A. DNA Melting Analysis. Mol. Aspects Med. 2024, 97, 101268. [Google Scholar] [CrossRef] [PubMed]
- Rehman, S.U.; Sarwar, T.; Husain, M.A.; Ishqi, H.M.; Tabish, M. Studying Non-Covalent Drug-DNA Interactions. Arch. Biochem. Biophys. 2015, 576, 49–60. [Google Scholar] [CrossRef] [PubMed]
- Rodrigues, B.M.; Victória, H.F.V.; Leite, G.; Krambrock, K.; Chaves, O.A.; de Oliveira, D.F.; Garcia, R.d.Q.; de Boni, L.; Costa, L.A.S.; Iglesias, B.A. Photophysical, Photobiological, and Biomolecule-Binding Properties of New Tri-Cationic Meso-Tri(2-Thienyl)Corroles with Pt(II) and Pd(II) Polypyridyl Derivatives. J. Inorg. Biochem. 2023, 242, 112149. [Google Scholar] [CrossRef]
- Sakthikumar, K.; Solomon, R.V.; Raja, J.D. Spectro-Electrochemical Assessments of DNA/BSA Interactions, Cytotoxicity, Radical Scavenging and Pharmacological Implications of Biosensitive and Biologically Active Morpholine-Based Metal(II) Complexes: A Combined Experimental and Computational Investigation. RSC Adv. 2019, 9, 14220–14241. [Google Scholar] [CrossRef]
- Kashanian, S.; Askari, S.; Ahmadi, F.; Omidfar, K.; Ghobadi, S.; Tarighat, F.A. In Vitro Study of DNA Interaction with Clodinafop-Propargyl Herbicide. DNA Cell Biol. 2008, 27, 581–586. [Google Scholar] [CrossRef]
- Papastergiou, A.; Perontsis, S.; Gritzapis, P.; Koumbis, A.E.; Koffa, M.; Psomas, G.; Fylaktakidou, K.C. Evaluation of O-Alkyl and Aryl Sulfonyl Aromatic and Heteroaromatic Amidoximes as Novel Potent DNA Photo-Cleavers. Photochem. Photobiol. Sci. 2016, 15, 351–360. [Google Scholar] [CrossRef]
- Tarushi, A.; Lafazanis, K.; Kljun, J.; Turel, I.; Pantazaki, A.A.; Psomas, G.; Kessissoglou, D.P. First- and Second-Generation Quinolone Antibacterial Drugs Interacting with Zinc(II): Structure and Biological Perspectives. J. Inorg. Biochem. 2013, 121, 53–65. [Google Scholar] [CrossRef]
- Tarushi, A.; Kljun, J.; Turel, I.; Pantazaki, A.A.; Psomas, G.; Kessissoglou, D.P. Zinc(II) Complexes with the Quinolone Antibacterial Drug Flumequine: Structure, DNA- and Albumin-Binding. New J. Chem. 2013, 37, 342–355. [Google Scholar] [CrossRef]
- Merlot, A.M.; Kalinowski, D.S.; Richardson, D.R. Unraveling the Mysteries of Serum Albumin—More than Just a Serum Protein. Front. Physiol. 2014, 5, 299. [Google Scholar] [CrossRef]
- Cho, H.; Jeon, S.I.; Ahn, C.H.; Shim, M.K.; Kim, K. Emerging Albumin-Binding Anticancer Drugs for Tumor-Targeted Drug Delivery: Current Understandings and Clinical Translation. Pharmaceutics 2022, 14, 728. [Google Scholar] [CrossRef] [PubMed]
- Stella, L.; Capodilupo, A.L.; Bietti, M. A Reassessment of the Association between Azulene and [60] Fullerene. Possible Pitfalls in the Determination of Binding Constants through Fluorescence Spectroscopy. Chem. Commun. 2008, 4744–4746. [Google Scholar] [CrossRef]
- Wang, Y.-Q.; Zhang, H.-M.; Zhang, G.-C.; Tao, W.-H.; Tang, S.-H. Interaction of the Flavonoid Hesperidin with Bovine Serum Albumin: A Fluorescence Quenching Study. J. Lumin. 2007, 126, 211–218. [Google Scholar] [CrossRef]
- Laitinen, O.H.; Hytonen, V.P.; Nordlund, H.R.; Kulomaa, M.S. Genetically Engineered Avidins and Streptavidins. Cell. Mol. Life Sci. 2006, 63, 2992–3017. [Google Scholar] [CrossRef]
- Sudlow, G.; Birkett, D.J.; Wade, D.N. Further Characterization of Specific Drug Binding Sites on Human Serum Albumin. Mol. Pharmacol. 1976, 12, 1052–1061. [Google Scholar] [CrossRef] [PubMed]
- Lazou, M.; Tarushi, A.; Gritzapis, P.; Psomas, G. Transition Metal Complexes with a Novel Guanine-Based (E)-2-(2-(Pyridin-2-Ylmethylene)Hydrazinyl)Quinazolin-4(3H)-One: Synthesis, Characterization, Interaction with DNA and Albumins and Antioxidant Activity. J. Inorg. Biochem. 2020, 206, 111019. [Google Scholar] [CrossRef]
- Reichmann, M.E.; Rice, S.A.; Thomas, C.A.; Doty, P. A Further Examination of the Molecular Weight and Size of Desoxypentose Nucleic Acid. J. Am. Chem. Soc. 1954, 76, 3047–3053. [Google Scholar] [CrossRef]
- Bruker Analytical X-ray Systems Inc. Apex2 Version 2 User Manual M86-E01078; Bruker Analytical X-ray Systems: Madison, WI, USA, 2006. [Google Scholar]
- Sheldrick, G.M. SADABS: Area-Detector Absorption Correction; University of Gottingen: Gottingen, Germany, 1996. [Google Scholar]
- Palatinus, L.; Chapuis, G. SUPERFLIP—A Computer Program for the Solution of Crystal Structures by Charge Flipping in Arbitrary Dimensions. J. Appl. Crystallogr. 2007, 40, 786–790. [Google Scholar] [CrossRef]
- Betteridge, P.W.; Carruthers, J.R.; Cooper, R.I.; Prout, K.; Watkin, D.J. CRYSTALS Version 12: Software for Guided Crystal Structure Analysis. J. Appl. Crystallogr. 2003, 36, 1487. [Google Scholar] [CrossRef]
- De Meulenaer, J.; Tompa, H. The Absorption Correction in Crystal Structure Analysis. Acta Crystallogr. 1965, 19, 1014–1018. [Google Scholar] [CrossRef]

| Bond | Length (Å) | Bond | Distance (Å) |
| Co1—O1 | 2.0391 (19) | O1—C1 | 1.260 (3) |
| Co1—O3 | 2.0966 (19) | O2—C1 | 1.264 (3) |
| Co1—O4 | 2.1253 (17) | ||
| Bonds | Angle (°) | Bonds | Angle (°) |
| O1—Co1—O4 | 88.86 (8) | O3—Co1—O4 | 92.50 (8) |
| O1—Co1—O3 | 90.58 (8) | O3 i—Co1—O4 | 87.50 (8) |
| O1 i—Co1—O3 | 89.42 (8) | O1 i—Co1—O4 | 91.14 (8) |
| Compound | DPPH%, 30 min/60 min | ABTS% | H2O2% |
|---|---|---|---|
| 4′-Br-fenH | Not active | 0.84 ± 0.54 | 65.60 ± 0.76 |
| Complex 1 | Not active | 96.02 ± 0.64 | 64.74 ± 0.93 |
| Complex 2 | 3.93 ± 0.59/8.29 ± 0.71 | 94.93 ± 0.24 | 60.43 ± 0.04 |
| Complex 3 | Not active | 87.52 ± 0.63 | 96.93 ± 0.53 |
| Complex 4 | 3.37 ± 0.38/10.47 ± 0.44 | 81.86 ± 0.26 | 59.20 ± 0.24 |
| Complex 5 | Not active | 89.18 ± 0.45 | 58.85 ± 0.22 |
| Complex 6 | Not active | 93.34 ± 0.61 | 76.94 ± 0.22 |
| Complex 7 | Not active | 96.23 ± 0.14 | 82.73 ± 0.78 |
| Complex 8 | Not active | 95.84 ± 0.11 | 71.70 ± 0.55 |
| Complex 9 | 21.98 ± 0.11/35.65 ± 1.05 | 96.48 ± 0.07 | 74.74 ± 0.38 |
| NDGA | 93.51 ± 1.28/92.68 ± 0.86 | Not tested | Not tested |
| BHT | 70.23 ± 9.50/86.54 ± 0.53 | Not tested | Not tested |
| trolox | Not tested | 98.10 ± 0.48 | Not tested |
| L-ascorbic acid | Not tested | Not tested | 58.90 ± 0.52 |
| Compound | P. aeruginosa | E. coli | S. epidermidis | S. aureus | ||||
|---|---|---|---|---|---|---|---|---|
| MIC (μΜ) | MBC (μΜ) | MIC (μΜ) | MBC (μΜ) | MIC (μΜ) | MBC (μΜ) | MIC (μΜ) | MBC (μΜ) | |
| 4′-Br-fenH | >250 | - | 207.9 ± 8.7 | >250 | 215.3 ± 1.5 | >250 | 250 ± 0.0 | >250 |
| Complex 1 | >250 | - | 79.5 ± 11.5 | >200 | 168.1 ± 18.6 | 200 | 146.6 ± 16.1 | >200 |
| Complex 2 | >250 | - | 30.4 ± 7.1 | >250 | 60.5 ± 2.1 | >250 | 56.4 ± 1.0 | >250 |
| Complex 3 | >250 | - | 20.0 ± 0.0 | >250 | 74.6 ± 0.9 | >250 | 50.3 ± 0.8 | >250 |
| Complex 4 | >250 | - | 85.3 ± 3.3 | 133 ± 33 | 106.5 ± 2.4 | >250 | 128.7 ± 1.0 | 250 |
| Complex 5 | >250 | - | 115.7 ± 5.1 | 205 ± 30 | 94.7 ± 7.3 | >250 | 98.0 ± 1.3 | >250 |
| Complex 6 | >250 | - | 44.8 ± 4.9 | >250 | 98.9 ± 11.1 | >250 | 99.1 ± 3.3 | >250 |
| Complex 7 | >250 | - | 20.1 ± 0.2 | >250 | 97.4 ± 2.0 | >250 | 61.1 ± 7.7 | 250 |
| Complex 8 | >250 | - | 78.5 ± 6.5 | 75 ± 19 | 107.8 ± 0.9 | >250 | 64.8 ± 5.6 | 115 ± 39 |
| Complex 9 | >250 | - | 66.3 ± 7.4 | >200 | 197.4 ± 24.6 | 200 | 149.8 ± 18.4 | 150 |
| MBC/MIC | IZ (mm) | MBC/MIC | IZ (mm) | MBC/MIC | IZ (mm) | MBC/MIC | IZ (mm) | |
| 4′-Br-fenH | - | 9.0 ± 0.0 | - | 9.0 ± 0.0 | - | 9.0 ± 0.0 | - | 9.0 ± 0.0 |
| Complex 1 | - | 9.1 ± 0.2 | - | 12.8 ± 0.5 | 1.2 | 10.8 ± 0.8 | - | 9.8 ± 0.9 |
| Complex 2 | - | 9.0 ± 0.0 | - | 12.8 ± 0.9 | - | 11.5 ± 0.9 | - | 12.0 ± 0.0 |
| Complex 3 | - | 9.0 ± 0.0 | - | 16.1 ± 1.2 | - | 19.5 ± 0.9 | - | 16.7 ± 1.3 |
| Complex 4 | - | 9.0 ± 0.0 | 1.6 | 10.9 ± 0.8 | - | 9.3 ± 0.5 | - | 12.0 ± 1.1 |
| Complex 5 | - | 9.3 ± 0.5 | 1.8 | 12.0 ± 1.1 | - | 9.8 ± 0.5 | - | 10.4 ± 0.7 |
| Complex 6 | - | 9.0 ± 0.0 | - | 11.3 ± 0.7 | - | 9.0 ± 0.0 | - | 11.5 ± 0.9 |
| Complex 7 | - | 9.0 ± 0.0 | - | 10.8 ± 0.5 | - | 9.8 ± 1.1 | 4.1 | 11.9 ± 0.6 |
| Complex 8 | - | 9.0 ± 0.0 | 1.0 | 11.9 ± 0.8 | - | 10.0 ± 0.9 | 1.8 | 11.3 ± 0.7 |
| Complex 9 | - | 9.2 ± 0.5 | - | 13.3 ± 0.5 | 1.0 | 9.4 ± 0.5 | 1.0 | 9.8 ± 0.9 |
| Compound | λmax (nm) (ΔA/A0 (%)) a, Δλ (nm) b) | Kb (M−1) | Tm (°C) |
|---|---|---|---|
| 4′-Br-fenH | 301 (+8, a +9 b); 347 (−40, elim c) | 4.42 (±0.30) × 104 | 82.6 |
| Complex 1 | 304 (+5, a +2 b) | 8.90 (±0.19) × 105 | 84.3 |
| Complex 2 | 285 (−5, 0); 311 (−5, −2) | 6.73 (±0.20) × 105 | 84.8 |
| Complex 3 | 286 (+13, 0); 312 (+10, +2) | 7.92 (±0.35) × 105 | 85.0 |
| Complex 4 | 297 (+5, +6); 347 (−20, elim) | 9.92 (±0.14) × 105 | 87.7 |
| Complex 5 | 285 (−10, +20) | 3.61 (±0.10) × 105 | 83.5 |
| Complex 6 | 307 (+3, +3); 350 (−30, elim) | 2.00 (±0.07) × 106 | 85.7 |
| Complex 7 | 311 (−15, 0) | 1.56 (±0.07) × 106 | 83.8 |
| Complex 8 | 306 (−11, −1) | 1.21 (±0.19) × 106 | 84.5 |
| Complex 9 | 308 (−2, 0) | 9.37 (±0.65) × 105 | 84.6 |
| Compound | ΔI/I0 (%) | KSV (M−1) | Kq (M−1s−1) |
|---|---|---|---|
| 4′-Br-fenH | 39.1 | 2.59 (±0.07) × 104 | 1.13 (±0.03) × 1012 |
| Complex 1 | 56.8 | 5.74 (±0.03) × 104 | 2.49 (±0.11) × 1012 |
| Complex 2 | 63.5 | 1.13 (±0.04) × 105 | 4.90 (±0.17) × 1012 |
| Complex 3 | 66.6 | 1.11 (±0.04) × 105 | 4.84 (±0.16) × 1012 |
| Complex 4 | 70.5 | 1.52 (±0.05) × 105 | 6.60 (±0.23) × 1012 |
| Complex 5 | 57.8 | 1.27 (±0.07) × 105 | 5.53 (±0.30) × 1012 |
| Complex 6 | 65.5 | 5.78 (±0.20) × 104 | 2.51 (±0.09) × 1012 |
| Complex 7 | 68.3 | 6.42 (±0.22) × 104 | 2.79 (±0.09) × 1012 |
| Complex 8 | 66.2 | 9.90 (±0.34) × 104 | 4.31 (±0.15) × 1012 |
| Complex 9 | 74.2 | 4.45 (±0.15) × 104 | 1.94 (±0.07) × 1012 |
| Compound | Kq (BSA) (M−1s−1) | K(BSA) (M−1) | K(BSA, warfarin) (M−1) | K(BSA, ibuprofen) (M−1) |
| 4′-Br-fenH | 1.74 (±0.09) × 1013 | 2.72 (±0.09) × 105 | 1.65 (±0.06) × 105 | 1.79 (±0.05) × 105 |
| Complex 1 | 2.90 (±0.09) × 1013 | 3.24 (±0.11) × 105 | 2.46 (±0.05) × 105 | 2.97 (±0.11) × 105 |
| Complex 2 | 3.21 (±0.09) × 1013 | 3.45 (±0.12) × 105 | 2.13 (±0.05) × 105 | 3.04 (±0.11) × 105 |
| Complex 3 | 3.43 (±0.05) × 1013 | 3.00 (±0.08) × 105 | 3.20 (±0.10) × 105 | 2.70 (±0.07) × 105 |
| Complex 4 | 4.88 (±0.12) × 1013 | 3.84 (±0.08) × 105 | 1.36 (±0.06) × 105 | 1.45 (±0.08) × 105 |
| Complex 5 | 3.69 (±0.09) × 1013 | 3.38 (±0.10) × 105 | 1.23 (±0.04) × 105 | 1.32 (±0.04) × 105 |
| Complex 6 | 4.65 (±0.07) × 1013 | 3.95 (±0.14) × 105 | 2.75 (±0.05) × 105 | 2.16 (±0.06) × 105 |
| Complex 7 | 5.34 (±0.39) × 1013 | 5.00 (±0.15) × 105 | 1.01 (±0.05) × 105 | 2.02 (±0.06) × 105 |
| Complex 8 | 6.23 (±0.09) × 1013 | 4.69 (±0.13) × 105 | 1.02 (±0.05) × 105 | 6.11 (±0.37) × 105 |
| Complex 9 | 3.89 (±0.72) × 1013 | 3.72 (±0.84) × 105 | 3.47 (±0.11) × 105 | 3.10 (±0.10) × 105 |
| Compound | Kq (HSA) (M−1s−1) | K(HSA) (M−1) | K(HSA, warfarin) (M−1) | K(HSA, ibuprofen) (M−1) |
| 4′-Br-fenH | 1.52 (±0.75) × 1013 | 2.70 (±0.06) × 105 | 1.96 (±0.06) × 105 | 2.26 (±0.07) × 105 |
| Complex 1 | 2.14 (±0.01) × 1013 | 4.77 (±0.15) × 105 | 2.32 (±0.88) × 105 | 2.94 (±0.15) × 105 |
| Complex 2 | 2.36 (±0.08) × 1013 | 3.60 (±0.10) × 105 | 1.14 (±0.04) × 105 | 3.10 (±0.08) × 105 |
| Complex 3 | 2.43 (±0.11) × 1013 | 3.83 (±0.09) × 105 | 2.22 (±0.10) × 105 | 2.85 (±0.10) × 105 |
| Complex 4 | 2.43 (±0.14) × 1013 | 3.80 (±0.10) × 105 | 4.62 (±0.15) × 105 | 3.46 (±0.12) × 105 |
| Complex 5 | 2.36 (±0.08) × 1013 | 2.90 (±0.11) × 105 | 4.57 (±0.14) × 105 | 3.74 (±0.16) × 105 |
| Complex 6 | 6.32 (±0.16) × 1013 | 5.82 (±0.23) × 105 | 4.92 (±0.25) × 105 | 9.53 (±0.21) × 105 |
| Complex 7 | 5.45 (±0.16) × 1013 | 7.15 (±0.15) × 105 | 5.34 (±0.20) × 105 | 3.52 (±0.21) × 105 |
| Complex 8 | 5.82 (±0.21) × 1013 | 6.20 (±0.18) × 105 | 7.19 (±0.23) × 105 | 10.20 (±0.30) × 105 |
| Complex 9 | 5.21 (±0.09) × 1013 | 5.58 (±0.15) × 105 | 4.57 (±0.14) × 105 | 6.51 (±0.23) × 105 |
Disclaimer/Publisher’s Note: The statements, opinions and data contained in all publications are solely those of the individual author(s) and contributor(s) and not of MDPI and/or the editor(s). MDPI and/or the editor(s) disclaim responsibility for any injury to people or property resulting from any ideas, methods, instructions or products referred to in the content. |
© 2025 by the authors. Licensee MDPI, Basel, Switzerland. This article is an open access article distributed under the terms and conditions of the Creative Commons Attribution (CC BY) license (https://creativecommons.org/licenses/by/4.0/).
Share and Cite
Malis, G.; Banti, C.N.; Tialiou, A.; Reithofer, M.R.; Hatzidimitriou, A.G.; Hadjikakou, S.K.; Fylaktakidou, K.C.; Psomas, G. Cobalt(II) Complexes of 4′-Bromo-Fenamic Acid: Antioxidant Properties, Antibacterial Activity, and Interaction with DNA and Albumins. Int. J. Mol. Sci. 2025, 26, 9787. https://doi.org/10.3390/ijms26199787
Malis G, Banti CN, Tialiou A, Reithofer MR, Hatzidimitriou AG, Hadjikakou SK, Fylaktakidou KC, Psomas G. Cobalt(II) Complexes of 4′-Bromo-Fenamic Acid: Antioxidant Properties, Antibacterial Activity, and Interaction with DNA and Albumins. International Journal of Molecular Sciences. 2025; 26(19):9787. https://doi.org/10.3390/ijms26199787
Chicago/Turabian StyleMalis, Georgios, Christina N. Banti, Alexia Tialiou, Michael R. Reithofer, Antonios G. Hatzidimitriou, Sotiris K. Hadjikakou, Konstantina C. Fylaktakidou, and George Psomas. 2025. "Cobalt(II) Complexes of 4′-Bromo-Fenamic Acid: Antioxidant Properties, Antibacterial Activity, and Interaction with DNA and Albumins" International Journal of Molecular Sciences 26, no. 19: 9787. https://doi.org/10.3390/ijms26199787
APA StyleMalis, G., Banti, C. N., Tialiou, A., Reithofer, M. R., Hatzidimitriou, A. G., Hadjikakou, S. K., Fylaktakidou, K. C., & Psomas, G. (2025). Cobalt(II) Complexes of 4′-Bromo-Fenamic Acid: Antioxidant Properties, Antibacterial Activity, and Interaction with DNA and Albumins. International Journal of Molecular Sciences, 26(19), 9787. https://doi.org/10.3390/ijms26199787

